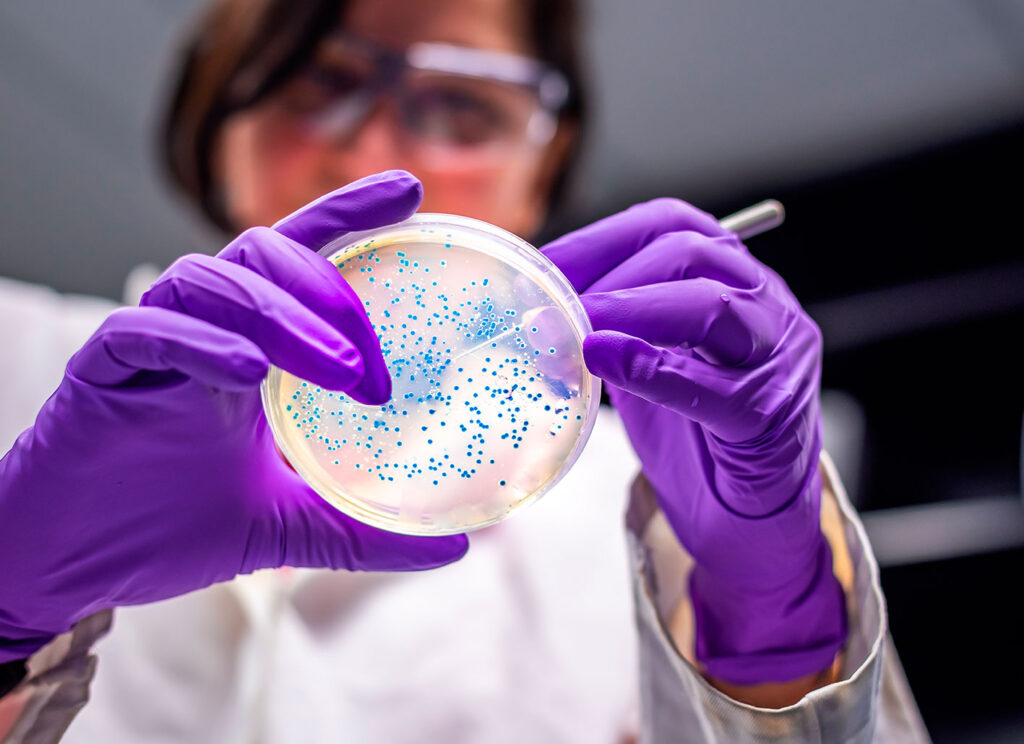
laboratorio-viro-sanity laboratorio-viro-sanity

TOTAL PROTECTION PROCESS
Percorso Produttivo Integrato di Sanificazione Materassi

La sinergia di più tecnologie con un unico scopo:
“la totale sanificazione del prodotto”
Quello che è successo all’intera popolazione del pianeta ci ha colpito seriamente e ci ha spinto a metterci in moto per sviluppare un percorso integrato che attiva al proprio interno le più moderne tecnologie sanificanti.
Il nostro interesse si è sviluppato in una ricerca scientifica tradotta in una vera e propria rivoluzione tecnologica, grazie alla collaborazione con centri di ricerca internazionale.
POSSIAMO DORMIRE SONNI TRANQUILLI?
Ne siamo così certi?
Quando andiamo a riposare cerchiamo di regalarci un sonno tranquillizzante e ci sentiamo, tutto sommato al riparo in un ambiente protetto, ma non sempre è così. Infatti, proprio il nostro amato letto può essere il luogo dove si annidano, prosperano e vivono virus, batteri, acari e muffe.


Virus
Clicca e scopri di più
Virus
Sono piccoli parassiti cioè elementi genetici che invadono una cellula per completare il proprio ciclo vitale, proprio quando le cellule colpite si replicano, procurano la diffusione del virus e la conseguente infezione.
Tutti i virus presentano un codice genetico, ma non si riproducono autonomamente, hanno bisogno di una cellula ospite.

Virus Avvolti
Clicca e scopri di più
Virus
Esistono in natura virus formati da acidi nucleici, ma esistono anche altre particelle virali che all'esterno presentano una membrana che le avvolge, come un proprio rivestimento. Tra queste sono comprese i coronavirus.
Dato che non hanno una parete cellulare e un proprio metabolismo, non risentono dell'azione degli antibiotici.

Batteri
Clicca e scopri di più
Batteri
Sono organismi unicellulari viventi molto piccoli, nell'ordine del millesimo di millimetro, si trovano ovunque e sono di varia forma.
Nel caso in cui producano sostanze tossiche assumono il termine di patogeni, che indica la capacità di un batterio di moltiplicarsi in un organismo recando danno all'ospite.

Acari e allergeni
Clicca e scopri di più
Acari e allergeni
Gli acari sono responsabili del 75% di tutte le allergie respiratorie.
Comportano sintomi tipici come:
raffreddore, congiuntivite, starnuti e occhi arrossati.
L'infezione in alcuni casi può addirittura diventare cronica quando gli acari sono presenti tutto l'anno.

Cimici del letto
Clicca e scopri di più
Cimici del letto
Si tratta di insetti che si nutrono di sangue.
Durante il giorno si mantengono nascosti nelle loro tane annidandosi nei tessuti e agiscono negativamente durante la notte.
Non sono particolarmente pericolose per la salute e non trasmettono malattie, ma possono provocare fastidiose irritazioni cutanee.

Muffa
Clicca e scopri di più
Muffa
Sono organismi pluricellulari, appartengono alla categoria dei funghi, producono particelle sferiche che si chiamano spore e si diffondono nell'aria. I sintomi possono essere quelli legati all'apparato respiratorio come asma e danni funzionali alla respirazione.
Possono causare fastidiose irritazioni agli occhi e alla pelle.


FATTORI DI RISCHIO E PROLIFERAZIONE
Calore, umidità, grassi e proteine
Esistono 4 fattori che favoriscono la proliferazione dei batteri e sono appunto umidità, calore. grassi e proteine.
La dispersione del sudore umano è il mezzo che favorisce la loro riproduzione sulle superfici dei tessuti che li accolgono.
Come Proliferano i batteri?
Essendo veri e propri esseri viventi cioè in grado di riprodursi in modo autonomo, proliferano in ambienti caldo/umidi cioé con delle temperature compresa tra 10/15 gradi C e 40/45 gradi C. I materassi costituiscono quindi l'ambiente ideale per la loro vita perché a causa della sudorazione del corpo, i tessuti rimangono umidi e costituiscono una dimora per tutti i batteri.
Quanto i virus rimangono sul tessuto?
Se analizziamo le goccioline che contengono i virus possiamo evincerne che rimangono infette per varie ore, dalle 8 alle 12.
A determinare la durata contribuiscono comunque vari fattori come: temperatura, umidità, tipo di superficie e qualità degli stessi virus.
Perché cambiare un vecchio materasso?
Batteri e virus sono una conseguenza inevitabile dovuta all'utilizzo quotidiano del materasso. Buona norma è quella di un'accurata pulizia per aiutare a minimizzare la loro proliferazione, ma comunque la sostituzione del materasso è un perfetto rimedio per assicurarsi sonni tranquilli e un riposo sicuro.

LA SINERGIA DI PIU'
TECNOLOGIE SANIFICANTI
Grandi risultati grazie alla ricerca applicata
Innovazione come motore di crescita per il benessere diffuso delle persone, attuata attraverso l'analisi di progetti e l'individuazione degli strumenti più idonei per offrire soluzioni soddisfacenti e valide sul lato sanitario.
1°
Il nostro stabilimento è stato completamente sanificato con apparecchiature professionali, in grado di garantire i massimi standard di igiene aziendale.
2°
Abbiamo realizzato un sistema produttivo con uno speciale iter procedurale che prevede un protocollo di sanificazione del prodotto con un doppio sistema tecnologico ed innovativo.
3°
Nell'intento di voler trasformare i parametri di sanificazione tradizionale del prodotto abbiamo aggiunto una speciale sanificazione che prevede l'utilizzo di raggi UV-C per raggiungere i livelli mai visti di efficacia.
4°
L'introduzione di trattamenti specifici su tessuti non è altro che il nostro modo per offrire un livello di sicurezza altissimo, perché costituisce una misura necessaria per mantenere nel tempo una valida barriera alla diffusione di batteri e virus.
5°
Tutte le nostre lavorazioni vengono garantite dalla presenza di un apposito sigillo applicato sull'involucro di ogni nostro prodotto, attestante le sanificazioni effettuate al fine di ridurre la presenza di elementi patogeni.


SIAMO AFFIANCATI DA LABORATORI PROFESSIONALI
Relazioni effettuate da professionisti certificati
Ci affidiamo a strutture specializzate in analisi che richiedono capacità e correttezza di linguaggio perché la precisione in quello che dichiariamo non deve trascurare le prove chiare in ordine ai risultati e all’efficacia delle soluzioni da noi proposte e opportunamente analizzate.
ANALISI E TEST DI LABORATORIO PER CERTIFICARE L'EFFICACIA
1° Test: Materasso usato da qualche anno
L'analisi di laboratorio è stata realizzata su due precisi campioni di materassi usati da circa 5 anni, uno con molle e l'altro in materiale memory. I test hanno evidenziato la presenza di un numero elevatissimo di colonie di batteri in entrambi i campioni.
2° Test: Materasso nuovo
senza trattamento
L'analisi effettuata su un materasso nuovo ha evidenziato l'esistenza di batteri in misura minima rispetto ai materassi usati, ma ne certificano la presenza. Questo sta a significare l'esigenza di realizzare opportune procedure di sanificazione.
3° Test: Materasso nuovo
trattato con Total protection process
Gli esami su materassi e cover trattati con il nostro sistema hanno evidenziato dei risultati strabilianti che permettono un'efficacia altissima e risultano quindi di assoluta necessità per garantire prodotti non solo puliti, ma sanificati ad altissimi livelli di igiene.

Clicca e scopri di più
Test di verifica contaminazione microbica totale
Effettuato su rivestimento esterno materasso a molle usato
Carica batterica totale a 30°C
UNI EN ISO 4833-1-2013
Risultato: 69.000 ufc/g

Clicca e scopri di più
Test di verifica contaminazione microbica totale
Effettuato su rivestimento esterno materasso a molle nuovo sanificato
Carica batterica totale a 30°C
UNI EN ISO 4833-1-2013
Risultato: 150 ufc/g

Clicca e scopri di più
Test di verifica contaminazione microbica totale
Effettuato rivestimento esterno materasso memory usato
Carica batterica totale a 30°C
UNI EN ISO 4833-1-2013
Risultato: 41.000 ufc/g

Clicca e scopri di più
Test di verifica contaminazione microbica totale
Effettuato rivestimento esterno materasso memory nuovo sanificato
Carica batterica totale a 30°C
UNI EN ISO 4833-1-2013
Risultato: 240 ufc/g
DOUBLE SYSTEM SANIFICATION
Total Protection Process
Un grande macchinario dove coesistono più tecnologie rivolte all'ottenimento di una efficace sanificazione


Investire ha costituito la strada obbligata degli ultimi mesi, quando si è reso necessario dare risposte concrete ai nostri clienti in termini di salute e sanificazione.
Appoggiandoci a studi esterni di primaria fama internazionale, che sviluppano tecnologie statunitensi, abbiamo realizzato uno speciale apparato produttivo unico nel suo genere e capace di ottenere risultati efficaci di sanificazione apprezzabili e certificati.


DOUBLE SYSTEM SANIFICATION
Una doppia tecnologia innovativa per la sanificazione
I materassi vengono introdotti in una struttura di doppia sanificazione dove sono trattati con vari processi di ozonizzazione, fotocatalisi e raggi UV-C, poi nell'uscita dalla catena produttiva vengono imballati con procedimento normale o sottovuoto, dove viene fatto un ulteriore passaggio con l'ozono e applicato l'adesivo che ne certifica l'avvenuto processo
Tecnologia spaziale
In questo particolare momento storico ci troviamo di fronte a grandi scoperte nell'ambito tecnologico, dove l'innovazione e l'evoluzione sono permesse dall'applicazione di scoperte in area spaziale che ci permettono di interagire ed esprimere al meglio il nostro sviluppo, grazie alla comprensione di conoscenze in ambito tecnico-scientifico.

LA DOPPIA TECNOLOGIA DELLA SANIFICAZIONE
Innovazione come soluzione
Le conoscenze acquisite in tanti anni di esperienza, grazie all'integrazione fra varie tecnologie, ci hanno permesso di costruire un reparto speciale dedicato alla realizzazione di materassi che proteggano durante il sonno, riducendo al minimo la trasmissione di agenti patogeni, prodotti mai visti prima sul mercato e capaci di rivoluzionare perché efficaci sul piano virale e antibatterico.
Con il nostro sigillo di chiusura garantiamo un prodotto certificato e sicuro senza contaminanti e completamente sanificato
Speciale sigillo di chiusura:
Questa ulteriore certificazione garantisce la sterilizzazione totale e l’efficacia del trattamento.
Materasso sterilizzato dopo il trattamento Double System Sanification chiuso da un sigillo che ne preserva il trattamento.
Tecnologia sanificante con ossidazione del tutto naturale
L’ozono è il più potente ossidante in natura


Proprietà dell’ozono
L’ozono è un potentissimo ossidante e reagisce con le sostanze organiche insature, agendo come battericida.
Il principale utilizzo è quello della sanificazione di acqua ed aria, proprio per i suoi effetti combinati di potente battericida, fungicida e inattivante dei virus.


Come funziona questa tecnologia
L'ozono prodotto dal nostro generatore elimina in modo totalmente naturale e quindi senza l'utilizzo di qualsiasi sostanza chimica, batteri, virus e funghi.
Sanifica con questo sistema non solamente l'aria, ma anche le superfici ed essendo più pesante dell'aria penetra anche nei tessuti.
Dopo pochi minuti l'ozono torna ad essere ossigeno senza presentare sostanze tossiche e macchie, rilasciando una piacevole sensazione di pulito annusando il prodotto trattato.
Presidio naturale per la sterilizzazione riconosciuto dal Ministero della Salute
Il Ministero della Salute con protocollo del 31 Luglio 1996 n°24482, ha riconosciuto l’utilizzo dell’ozono nel trattamento dell’aria e dell’acqua, come presidio naturale per la sterilizzazione di ambienti contaminati da batteri, virus, spore, muffe ed acari.



Trattamento tessile efficace e sicuro
• ANTI-BATTERICOPERMANENTE • RIDUZIONE DELLE ATTIVITA' VIRALI • TESSUTI PURI E FRESCHI
Di cosa si tratta?
Viene garantita la protezione dei materiali e la massima funzionalità possibile offrendo un'eccellente protezione contro virus e batteri.
Come funziona questo trattamento sul tessuto
Si tratta di una combinazione esclusiva riguardante il trattamento di finitura del rivestimento dei materassi. Studi recenti hanno dimostrato che con questi trattamenti l'attività dei virus diminuisce nell'arco di 2 ore riducendosi fino al 97%.
Tessuti studiati per non irritare la pelle
I tessuti utilizzati e trattati hanno generato grande entusiasmo nei nostri clienti perché ne garantiscono qualità e funzionalità durevoli nel tempo, proteggendo inoltre dalle infestazioni di funghi, cattivi odori e garantendo la massima traspirabilità.


TRATTAMENTO PERMANENTE
Si tratta di una delle tecnologie più innovative esistenti al mondo, non provoca nessuna irritazione sulla pelle, può ridurre la carica virale fino al 97%.
- Fornisce una disattivazione dei virus
- Inibisce la replica di batteri e virus









